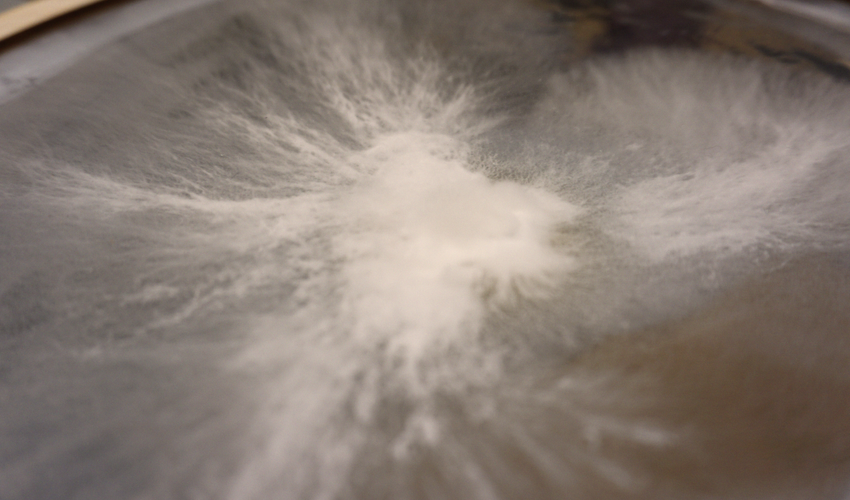

Hyfer
Light and living mycelium installation // 2021
Light installation and artistic exploration of mycelium.
Exhibited at Støberiet (Blågården, København) Dec 11th 2021 - Mar 5th 2022.

Hidden white thin treads moves slowly and persistent in the shadows. Living root-like veins spread in the darkness in clusters as networks in the underground where they feed from the dying and dead matter. The mycelium organism transforms dead material into new life. Mycelium is the fungi organism and hyfer its expanding veins. Through here passes drugs, chemicals and electrical pulses as communication and nutrition for those who are connected.